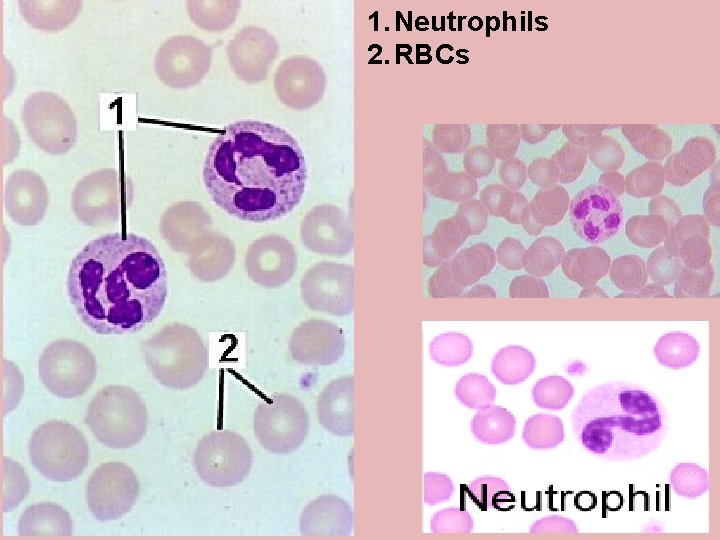
1. Neutrophils 2. RBCs
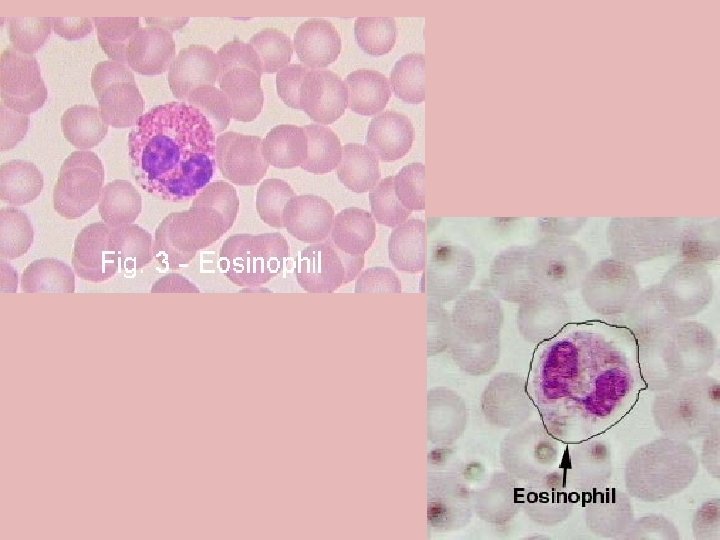
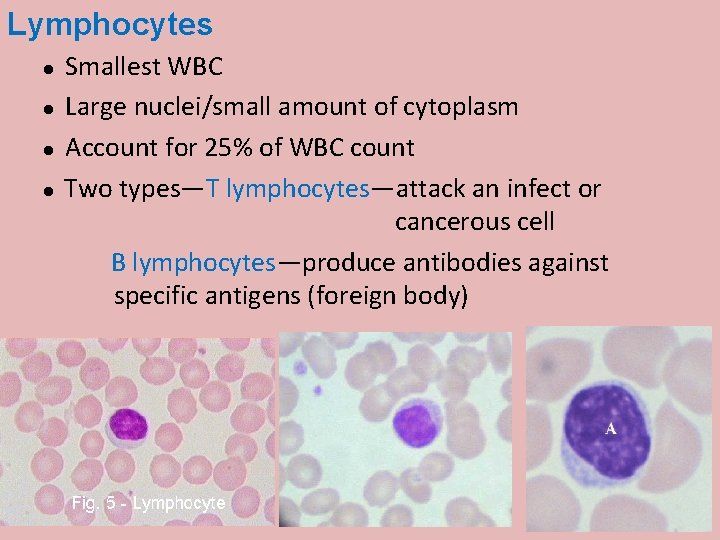
Lymphocytes Smallest WBC Large nuclei/small amount of cytoplasm Account for 25% of WBC count

Cardiovascular System CVS L1 Blood and Its Function

Cardiovascular System (CVS) L-1: Blood and Its Function Dr Than Kyaw 6 February 2012

Blood vascular system • Closed system • Blood Vessels – through which blood travels • Heart – pumps or pushes blood through body • Blood – mainly transport important substances through body

The Blood • Constitute 1. Cells: Erythrocytes (red blood cells; RBC) Leukocytes (white blood cells; WBC) Platelets (Thrombocytes) 2. Plasma Colloides (proteins) Electrolytes (Ca, Na, K, etc) Other substances (hormones, vitamins, etc) Formed elements

Functions of Blood • Transport - Nutrients absorbed from GI tract - O 2 – from lungs to cells of whole body - CO 2 - – from metabolized cells to lungs - Wastes - from metabolized cells to kidney - Hormones – from endocrine glands to target cells • Body temperature control • Maintenance of body fluid p. H (Buffering action) • Prevent blood loss (coagulation) • Prevent diseases (phagocytosis and antibody production)

Blood volume • Total amount of blood in an animal’s body including formed elements and plasma • Usually 8 – 10% of the body weight What will be the different percentages of - lean, muscular, or athletic animals and - fat animals Can blood volume be measured by bleeding?

The Hematocrit – Percent of packed cell volume (PCV) in whole blood – Measured as - Blood + anicoagulant in hematocrit tube - Centrifuge (11, 000 rpm; 5 min) - Usually buffy coat not counted

The Hematocrit values of animals – Percent of packed cell volume (PCV) in whole blood • • • Human - 45% in males; 42% in females Cow – 35% Horse – 41% Sheep – 35% Pig – 42% Dog – 45 Chicken – 30% White whale - 53% in females; 52% in males Pekin duck - 45% at seal level; 56% at high altitude Why is hematocrit value of animals higher at high altitude?

Blood p. H Average p. H value Arterial blood = 7. 4 Venous blood = 7. 36 Blood p. H should not be changed too much from normal. Why is p. H of venous blood lower than arterial blood?

Erythrocytes – Oblong oval or biconcaved flattened discs – Flexible – Contain no nucleus, orgennelles, or ribosomes – Contain plasma and hemoglobin RBCs of Birds and Fishes have nuclei

Erythrocytes • Transport O 2 and CO 2 • Color: due to O 2 carrying pigment: hemoglobin • Oxygen-rich blood is scarlet red • Contains oxyhemoglobin • Oxygen-poor blood is bluish • Contains deoxyhemoglobin Does not use the oxygen that they carry!

RBC Lifespan • • • Horse Cattle, Sheep, Goat Pig Dog Cat Chicken 140 – 150 125 – 160 75 – 95 100 – 120 70 – 80 20 - 30


Hemoglobin • Hemoglobin reversibly binds with O 2 and most O 2 in the blood is bound to hemoglobin • Composition of hemoglobin – A protein called globin • made up of two alpha and two beta chains – A heme molecule • Each heme group bears an atom of iron, which can bind to one oxygen molecule • Each hemoglobin molecule thus can transport four molecules of oxygen

Hemoglobin • Oxyhemoglobin – hemoglobin bound to oxygen – Oxygen loading takes place in the lungs • Deoxyhemoglobin – hemoglobin after oxygen diffuses into tissues (reduced Hb) • Carbaminohemoglobin – hemoglobin bound to CO 2 – CO 2 loading takes place in the tissues

Hemoglobin · Iron-containing protein (Hb + globin) Molecular weight of Hb = 67, 000 · Binds reversibly to oxygen · Each molecule has four oxygen binding sites · Each erythrocyte can carry 250 million hemoglobin molecules

Fate of Erythrocytes · Unable to divide, grow, or synthesize proteins · Wear out in 100 to 120 days · Removed by Monocyte-macrophage system (Also k/s RE-System=Reticulo-endothelial system or MPS = Mononuclear phagocytic system) After leaving the blood stream, the monocytes become fixed-macrophages in the sinusoids of liver, spleen, bone marrow and lymph nodes.

Senescent RBCs Hemolysed* RBCs In MPS cells releasing HB *What are hemolytic Fate of Erythrocytes agents? (bacterial toxins, snake venoms, blood parasites, hypotonic solutions)

Leukocytes (White Blood Cells) Properties · Play a role in immune response · Typical cells with nucleus, organelles · Able to move into & out of blood vessels by Diapedesis: Gr. “leaping through”

Leukocytes (White Blood Cells) Properties · Move by ameboid motion · Respond to chemicals released by damaged tissues · “chemotaxis” – chemical attraction · Allows for immune response

Types of Leukocytes Leucocytes: brightly colored in stained preparations, have a nuclei and are generally larger in size than RBC’s. Two categories – 1. Granulocytes & 2. Agranulocytes All together 5 cell types Classified by the +/- of granules and the staining characteristics of their cytoplasm.

Agranulocytes Granulocytes

Granulocytes have large granules in their cytoplasm Three types § Neutrophils § Eosinophils § Basophils


Neutrophils Stain light purple with neutral dyes Granules are small and numerous—course appearance Several lobes in nucleus 65% of WBC count Highly mobile/very active Diapedesis—Can leave blood vessels and enter tissue space Phagocytotic - contain several lysosomes
1. Neutrophils 2. RBCs

Eosinophils or Acidophils Large, numerous granules Nuclei with two lobes 2 -5% of WBC count Found in lining of respiratory and digestive tracts Important functions involve protections against infections caused by parasitic worms and involvement in allergic reactions Secrete anti-inflammatory substances in allergic reactions

Basophils Least numerous -- 0. 5 -1% Diapedesis — Can leave blood vessels and enter tissue space Contain histamine, serotonin, heparin— inflammatory chemical


Agranulocytes do not have granules in their cytoplasm Lymphocytes Monocytes
Lymphocytes Smallest WBC Large nuclei/small amount of cytoplasm Account for 25% of WBC count Two types—T lymphocytes—attack an infect or cancerous cell B lymphocytes—produce antibodies against specific antigens (foreign body)

Monocytes Largest of WBCs Dark kidney bean shaped nuclei Highly phagocytic Longer life span Found in chronic infection (long term defence)

White Blood Cells – Fight and kill germs that may enter blood stream


Lifespan of White Cells • Granulocytes – 6 – 20 h in blood 2 – 3 d in tissues - Once they leave blood, they normally do not return • Monocytes – 24 h in blood - several months in tissues - become fixed macrophages in sinusoids of liver, spleen, bone marrow and lymph nodes • Lymphocytes - T cells: 100 – 200 d B cells: 2 – 4 d Memory T and B cells (years) - lymphocytes repeatedly circulate from blood to tissues, to lymph and back to blood

Platelets (Thrombocytes)

Platelets • Platelets are fragments of megakaryocytes • Their granules contain serotonin, Ca 2+, enzymes, ADP, and platelet-derived growth factor (PDGF) • Platelets function in the clotting mechanism by forming a temporary plug that helps seal breaks in blood vessels • Platelets not involved in clotting are kept inactive by Nitric Oxide (NO) and prostaglandins

Hematopoiesis Formation of Blood Elements Erythropoiesis Hematopoiesis Leukopoiesis ● ● Formed in the red marrow of many bones. Also can be formed in lymphatic tissues.

Hematopoiesis • All blood cells originate from pluripotent stem cell hemocytoblasts – The mother of all blood stem cells • Hemocytoblasts differentiate into myeloid stem cells and lymphoid stem cells – Myeloid stem cells become myeloblasts or monoblasts • Granulocytes form from myeloblasts • Monoblasts enlarge and form monocytes – Lymphoid stem cells become lymphoblasts • Lymphoblasts develop into lymphocytes

All blood cells originate from pluripotent stem cell hemocytoblasts Pluripotent stem cells (Hemocytoblasts) Myeloid stem cells Rubriblast Erythrocytes Lymphoid stem cells Megakaryoblasts Myeloblast Monoblast Lymphoblast Thrombocytes Granulocytes (Neutrophils, Eosinophils, Basophils Monocytes Lymphocytes


Hormonal control of erythropoiesis Hypoxia (decreased RBCs) Decreased O 2 availability Increased tissue demand for O 2 Stimulate Erythropoietin (glycoprotein produced by kidney) Bone marrow Adequate supplies of iron, amino acids, and B vitamins Erythropoiesis


Erythropoiesis Dietary Requirements • Erythropoiesis requires: – Proteins, lipids, and carbohydrates – Iron, vitamin B 12, and folic acid • The body stores iron in Hb (65%), the liver, spleen, and bone marrow • Intracellular iron is stored in protein-iron complexes such as ferritin and hemosiderin • Circulating iron is loosely bound to the transport protein transferrin

Blood Groups and Transfusions • Large losses of blood have serious consequences • Loss of 15 to 30 % causes weakness • Loss of over 30 % causes shock, fatal • Seldom practiced in animal

Blood Groups and Transfusions · Transfusions are the only way to replace blood quickly · Transfused blood must be of the same blood group · Wrong group: dead patient · First done: William Harvey, England (1600’s? )

Blood Groups and Transfusions • RBCs carry genetically determined proteins • Called antigens (Ag) • Proteins embedded in cell membrane • A foreign protein (Ag) may be attacked by the immune system

Blood groups in animals and man • Animals have a variety of different blood types • Human 4 groups

Blood Groups of some animals Animal spp Blood groups Cattle A, B, C, F, J, L, M, R, S, T, Z 11 Goats A, B, C, M, J 5 Sheep A, B, C, D, M, R and X 7 Horse 8 major groups (A, C, D, K, P, Q, U, T) Over 30 Cat A, B, AB 3 Dog DEA 1. 1, 1. 2, 4, 5, 6, 7, 8 8 Human A, B, AB, O 4 DEA=Dog Erythrocyte Antigen

Blood Typing • Blood antigens – Type A – Type B • Agglutininins (Ab) – Act in blood typing – Antigen-antibody reaction

ABO Blood Groups · Based on the presence or absence of two antigens - Type A - Type B · The lack of both these antigens is called type O

ABO Blood Groups · The presence of A is called type A · The presence B is called type B · The presence of both A and B is called type AB

Blood Groups • Blood Types and their corresponding Abs – – Type A, anti-B Type B, Anti-A Type AB, neither Type O, both

Rh Blood Groups · Depends on presence or absence of Rh antigens (agglutinogen D) · Most Americans are Rh+ (85%) · Rest are Rh· Problems can occur in mixing Rh+ blood into a body with Rh– blood

Rh Dangers During Pregnancy · Called hemolytic disease of the newborn or Erythroblostosis fetalis · Danger is only when · the mother is Rh– · the father is Rh+ · the child inherits the Rh+ factor

Rh Dangers During Pregnancy · Problem in an Rh– mother carrying an Rh+ baby: · The first pregnancy usually proceeds without problems · At birth, mother may receive some of baby’s RBCs

Rh Dangers During Pregnancy · Mom’s immune system is sensitized · Makes antibodies against Rh · In a subsequent pregnancy: · Mother’s blood carries antibodies · Anti-Rh antibodies cross placenta · Attack the Rh+ blood in the fetus

Rh Dangers During Pregnancy · Erythroblostosis fetalis, or · Hemolytic disease of the newborn

Blood Groups and Transfusions · Large losses of blood have serious consequences · Loss of 15 to 30 percent causes weakness · Loss of over 30 percent causes shock, which can be fatal Copyright © 2003 Pearson Education, Inc. publishing as Benjamin Cummings Slide 10. 25

Blood Groups and Transfusions · Transfusions are the only way to replace blood quickly · Transfused blood must be of the same blood group · Wrong group: dead patient · First done: William Harvey, England (1600’s? ) Copyright © 2003 Pearson Education, Inc. publishing as Benjamin Cummings Slide 10. 25

Human Blood Groups · RBCs carry genetically determined proteins · Called antigens (Ag) · Proteins embedded in cell membrane · A foreign protein (Ag) may be attacked by the immune system

Human Blood Groups · How blood is “typed”: · Uses antibodies (Ab) · Made by body against foreign proteins · cause “different” blood to clump (agglutination)

Blood Typing

Blood Typing · Typing for Rh factors is done in the same manner · Cross matching · testing for agglutination of donor RBCs by the recipient’s serum · testing for agglutination of recipient RBCs by the donor’s serum Copyright © 2003 Pearson Education, Inc. publishing as Benjamin Cummings Slide 10. 30

Blood Typing Blood samples are mixed with anti-serum anti-A: “against” A antigens anti-B: “against” B antigens Presence/absence of agglutination determines blood type
- Slides: 65